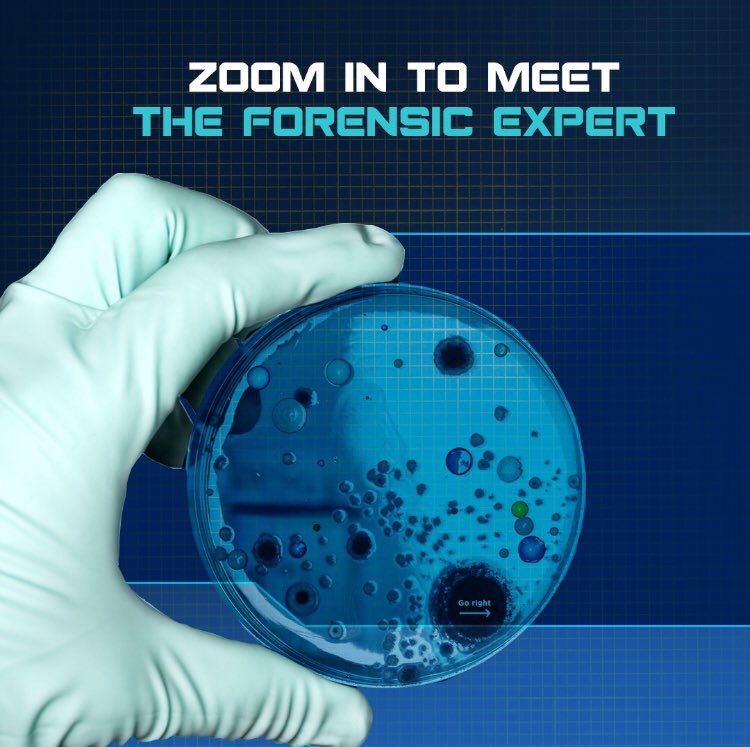

TSHOP |
- Change your thoughts and you will change your world. #quotes #inspire #mlmleads
- It sounds like a far-fetched plot from a Hollywood film but, as he tells...
- Metrics for B2B Website, Social Media, and Email Content business2community.com/b2b-marketing/… #smm #socialmedia #marketing
- Backend Developer (Multiple Levels Junior & Senior) @ gridX GmbH working-nomads.com/job/backend-de… #remotejobs #jobs #nomad...
- Go SDK Engineer @ Okta working-nomads.com/job/go-sdk-eng… #remotejobs #jobs #nomad #workfromhome #digitalnomad
- GREAT LEADERS ARE ABLE TO: clarify not confuse. build up not break down. unite...
- Backend Software Engineer (Go) - Amsterdam @ Stream working-nomads.com/job/backend-so… #remotejobs #jobs #nomad #workfromhome #digitalnomad
- 📆JOUR-J DE LA VENTE PRIVÉE : Ce samedi 12 Décembre à Renault NANTES. Renault...
- Software Development Engineer @ TUNE working-nomads.com/job/software-d… #remotejobs #jobs #nomad #workfromhome #digitalnomad
- Aston has set the bar impossibly high for its first SUV. Does the DBX...
- It can take years to get your life on the right path headed in...
- Go Backend Engineer (m/f/d) @ BlueGo working-nomads.com/job/go-backend… #remotejobs #jobs #nomad #workfromhome #digitalnomad
- #Qashqai her yere çok yakışıyor. Otoparka da öyle! #ParkEt #EvdeKal.
- Now available on #adidas US. adidas Ultra Boost 1.0 Reflective. —> bit.ly/2IzIkLV #ad
- Renault è sempre con te 💛La nostra Rete è aperta e con i nostri...
- 5 Things Every New Staffing Agency Needs to Know Before Getting Started akkencloud.com/staffingagenci… #staffing
- The drivers who will be taking the start in the 2020 @kyalami9hour at 11:00...
- @JainIrrigation Twin 95 Plus #Raingun @MPKVRahuri with Throwing Radius Range 23m to 54m Useful...
- श्रद्धेय पदमश्री डॉ. भवरलालजी जैन(मोठे भाऊ) यांच्या 83 व्या जयंतीनिमित्त विनम्र अभिवादन!! @ashokjainjal @JainIrrigation
- Remembering Late Padmashree Dr. Bhavarlal Ji Jain on his birthday will be complete only...
- #भारतीय_शेतीस #ठिंबक_सिंचनाची_संजीवनी देणारे #उद्योगपती #पद्मश्री #भंवरलालजी_जैन यांच्या जयंतीनिमित्त विनम्र #अभिवादन! @ashokjainjal @Jai...
- Use These Proven Steps to Enhance Your Recruitment Process akkencloud.com/recruitmentpro… #staffing
- With the arrival of the festive season, Oxford Bookstore brings you 12 handpicked books...
- Next stop @ymcofficial 💨 #AbuDhabiGP 🇦🇪
- Who's ready for the final Saturday of the season? 👊 #AbuDhabiGP 🇦🇪 | #WeAreWilliams...
- Coming through 👋 #AbuDhabiGP 🇦🇪
- Filtration: Selecting The Right System #moreCropPerDrop @JainIrrigation jainsusa.com/training/filtr…
- Discover our five tips to attract more customers to your coffee shop: Be present...
- Customer Centric Service at Jain Monitoring & Control #moreCropPerDrop @JainIrrigation jainsusa.com/training/custo…
- A watch for all seasons - especially Christmas. It's Tissot of course. martin-and-co.com #christmasshopping...
- No longer just a soapbox for shouting out opinions. Way beyond an advertising billboard....
- Sand 𝙚𝙫𝙚𝙧𝙮𝙬𝙝𝙚𝙧𝙚 ! 🤣 #AbuDhabiGP 🇦🇪
- I love audiobooks
- Backend Developer (Multiple Levels Junior & Senior) @ gridX GmbH working-nomads.com/job/backend-de… #remotejobs #jobs #nomad...
- @Banijayasia @deepak30000 @NegiR @Gashmeer #YudishthirSingh @poojaAgor @JaggiAshmita #KunalPant @shirazwriter @mantramugdh #SantoshShetty...
- Go SDK Engineer @ Okta working-nomads.com/job/go-sdk-eng… #remotejobs #jobs #nomad #workfromhome #digitalnomad
- Backend Software Engineer (Go) - Amsterdam @ Stream working-nomads.com/job/backend-so… #remotejobs #jobs #nomad #workfromhome #digitalnomad
- Just posted a photo @ Brighton and Hove instagram.com/p/CIsJahOleA1/…
- Software Development Engineer @ TUNE working-nomads.com/job/software-d… #remotejobs #jobs #nomad #workfromhome #digitalnomad
- An eye for detail is her forte and analysis is what she's best at!...
- Go Backend Engineer (m/f/d) @ BlueGo working-nomads.com/job/go-backend… #remotejobs #jobs #nomad #workfromhome #digitalnomad
- Nitrogen for Crops – How Much, What Type, and When to Apply #moreCropPerDrop @JainIrrigation...
- The Components of a Drip Irrigation System #moreCropPerDrop @JainIrrigation jainsusa.com/training/the-c…
- The Many Benefits of Cooling your Apple Crop #moreCropPerDrop @JainIrrigation jainsusa.com/training/the-m…
- Buone Feste ✨
- AudioThing Wave Box Sale (Exclusive) - 80% Off 🚀 🚀 pluginboutique.com/product/2-Effe… 🙌 👍 @PluginBoutique...
- Basic Operation and Maintenance of Irrigation Pumps for Landscape Irrigation #moreCropPerDrop @JainIrrigation jainsusa.com/training/basic…
- RT JainsUSA "Point Source or In-line Irrigation: Which one is right for my landscape?...
- RT JainsUSA "Fertilizer Management Using Today's Available Technology – Nitrogen #moreCropPerDrop @JainIrrigation jainsusa.com/training/...
- Not the only bandits in this desert 👀 #AbuDhabiGP 🇦🇪
| Change your thoughts and you will change your world. #quotes #inspire #mlmleads Posted: 12 Dec 2020 12:02 AM PST This posting includes an audio/video/photo media file: Download Now |
| It sounds like a far-fetched plot from a Hollywood film but, as he tells... Posted: 12 Dec 2020 12:02 AM PST It sounds like a far-fetched plot from a Hollywood film but, as he tells John Arlidge, former Nissan boss Carlos Ghosn's escape from house arrest was no work of fiction buff.ly/3m24Bjb This posting includes an audio/video/photo media file: Download Now |
| Posted: 12 Dec 2020 12:01 AM PST Metrics for B2B Website, Social Media, and Email Content business2community.com/b2b-marketing/… #smm #socialmedia #marketing This posting includes an audio/video/photo media file: Download Now |
| Posted: 12 Dec 2020 12:00 AM PST Backend Developer (Multiple Levels Junior & Senior) @ gridX GmbH working-nomads.com/job/backend-de… #remotejobs #jobs #nomad #workfromhome #digitalnomad This posting includes an audio/video/photo media file: Download Now |
| Posted: 12 Dec 2020 12:00 AM PST Go SDK Engineer @ Okta working-nomads.com/job/go-sdk-eng… #remotejobs #jobs #nomad #workfromhome #digitalnomad This posting includes an audio/video/photo media file: Download Now |
| GREAT LEADERS ARE ABLE TO: clarify not confuse. build up not break down. unite... Posted: 12 Dec 2020 12:00 AM PST GREAT LEADERS ARE ABLE TO: clarify not confuse. build up not break down. unite not divide. ~@LollyDaskal #Leadership #Management |
| Posted: 12 Dec 2020 12:00 AM PST Backend Software Engineer (Go) - Amsterdam @ Stream working-nomads.com/job/backend-so… #remotejobs #jobs #nomad #workfromhome #digitalnomad This posting includes an audio/video/photo media file: Download Now |
| 📆JOUR-J DE LA VENTE PRIVÉE : Ce samedi 12 Décembre à Renault NANTES. Renault... Posted: 12 Dec 2020 12:00 AM PST 📆JOUR-J DE LA VENTE PRIVÉE : Ce samedi 12 Décembre à Renault NANTES. Renault ZOE est à l'honneur en cette fin d'année.⚡ This posting includes an audio/video/photo media file: Download Now |
| Posted: 12 Dec 2020 12:00 AM PST Software Development Engineer @ TUNE working-nomads.com/job/software-d… #remotejobs #jobs #nomad #workfromhome #digitalnomad This posting includes an audio/video/photo media file: Download Now |
| Aston has set the bar impossibly high for its first SUV. Does the DBX... Posted: 12 Dec 2020 12:00 AM PST Aston has set the bar impossibly high for its first SUV. Does the DBX clear it? Read our review to find out pistonheads.com/news/ph-driven… @astonmartin #AstonMartin #DBX #PistonHeads This posting includes an audio/video/photo media file: Download Now |
| It can take years to get your life on the right path headed in... Posted: 12 Dec 2020 12:00 AM PST It can take years to get your life on the right path headed in the right direction, but it can take just a moment to ruin it. #ThinkFirst This posting includes an audio/video/photo media file: Download Now |
| Posted: 12 Dec 2020 12:00 AM PST Go Backend Engineer (m/f/d) @ BlueGo working-nomads.com/job/go-backend… #remotejobs #jobs #nomad #workfromhome #digitalnomad This posting includes an audio/video/photo media file: Download Now |
| #Qashqai her yere çok yakışıyor. Otoparka da öyle! #ParkEt #EvdeKal. Posted: 12 Dec 2020 12:00 AM PST This posting includes an audio/video/photo media file: Download Now |
| Now available on #adidas US. adidas Ultra Boost 1.0 Reflective. —> bit.ly/2IzIkLV #ad Posted: 12 Dec 2020 12:00 AM PST This posting includes an audio/video/photo media file: Download Now |
| Renault è sempre con te 💛La nostra Rete è aperta e con i nostri... Posted: 12 Dec 2020 12:00 AM PST Renault è sempre con te 💛La nostra Rete è aperta e con i nostri servizi digitali siamo sempre a tua disposizione 🚗➡️💻#OvunqueTuSia Scopri di più bit.ly/RenaultReteApe… Your browser does not support the video tag. Click here to view directly. This posting includes an audio/video/photo media file: Download Now |
| Posted: 11 Dec 2020 11:59 PM PST 5 Things Every New Staffing Agency Needs to Know Before Getting Started akkencloud.com/staffingagenci… #staffing |
| The drivers who will be taking the start in the 2020 @kyalami9hour at 11:00... Posted: 11 Dec 2020 11:59 PM PST The drivers who will be taking the start in the 2020 @kyalami9hour at 11:00 local time (CET+1): P4 @P_Niederhauser, R8 LMS #44 P7 Frédéric Vervisch, R8 LMS #32 P8 @m_winkelhock, R8 LMS #31 P12 Martin Lechman, R8 LMS #45 #PerformanceIsAnAttitude #GT3 #IntGTC #Kyalami9H This posting includes an audio/video/photo media file: Download Now |
| @JainIrrigation Twin 95 Plus #Raingun @MPKVRahuri with Throwing Radius Range 23m to 54m Useful... Posted: 11 Dec 2020 06:28 AM PST RT @pasalkarsidh @JainIrrigation Twin 95 Plus #Raingun @MPKVRahuri with Throwing Radius Range 23m to 54m Useful for Filed Crops like #Sugarcane ,#Tea, #Coffee #turf ,#Lawns & #Playground's @AjitJisl Ahmadnagar, India Your browser does not support the video tag. Click here to view directly. This posting includes an audio/video/photo media file: Download Now |
| Posted: 11 Dec 2020 06:17 PM PST RT @sandiptele श्रद्धेय पदमश्री डॉ. भवरलालजी जैन(मोठे भाऊ) यांच्या 83 व्या जयंतीनिमित्त विनम्र अभिवादन!! @ashokjainjal @JainIrrigation This posting includes an audio/video/photo media file: Download Now |
| Remembering Late Padmashree Dr. Bhavarlal Ji Jain on his birthday will be complete only... Posted: 11 Dec 2020 07:33 PM PST RT @sundaramnaraya1 Remembering Late Padmashree Dr. Bhavarlal Ji Jain on his birthday will be complete only with a renewed commitment to fulfil his teaching to leave this world better than you found it. Thanking @JainIrrigation for providing the opportunity. |
| Posted: 11 Dec 2020 07:45 PM PST RT @Rohini_khadse #भारतीय_शेतीस #ठिंबक_सिंचनाची_संजीवनी देणारे #उद्योगपती #पद्मश्री #भंवरलालजी_जैन यांच्या जयंतीनिमित्त विनम्र #अभिवादन! @ashokjainjal @JainIrrigation This posting includes an audio/video/photo media file: Download Now |
| Use These Proven Steps to Enhance Your Recruitment Process akkencloud.com/recruitmentpro… #staffing Posted: 11 Dec 2020 11:58 PM PST |
| With the arrival of the festive season, Oxford Bookstore brings you 12 handpicked books... Posted: 11 Dec 2020 11:56 PM PST With the arrival of the festive season, Oxford Bookstore brings you 12 handpicked books to read. @DeShobhaa @itsanandneel @karunaparikh @novoxeno #OxfordBookstore #OxfordRecommends #Books #Reading #Christmas #Christmas2020 #ApeejayGroup This posting includes an audio/video/photo media file: Download Now |
| Next stop @ymcofficial 💨 #AbuDhabiGP 🇦🇪 Posted: 11 Dec 2020 11:56 PM PST Next stop @ymcofficial 💨 #AbuDhabiGP 🇦🇪 Your browser does not support the video tag. Click here to view directly. This posting includes an audio/video/photo media file: Download Now |
| Who's ready for the final Saturday of the season? 👊 #AbuDhabiGP 🇦🇪 | #WeAreWilliams... Posted: 11 Dec 2020 11:54 PM PST This posting includes an audio/video/photo media file: Download Now |
| Coming through 👋 #AbuDhabiGP 🇦🇪 Posted: 11 Dec 2020 11:53 PM PST Coming through 👋 #AbuDhabiGP 🇦🇪 Your browser does not support the video tag. Click here to view directly. This posting includes an audio/video/photo media file: Download Now |
| Filtration: Selecting The Right System #moreCropPerDrop @JainIrrigation jainsusa.com/training/filtr… Posted: 11 Dec 2020 11:42 PM PST RT @JainsUSA Filtration: Selecting The Right System #moreCropPerDrop @JainIrrigation jainsusa.com/training/filtr… |
| Discover our five tips to attract more customers to your coffee shop: Be present... Posted: 11 Dec 2020 11:52 PM PST Discover our five tips to attract more customers to your coffee shop: Be present on social medias and post regularly Update your Google My Business profile Start email-marketing Ensure your website is mobile-ready Offer Wi-fi at your cafe Visit us at axalmedia.com/quote This posting includes an audio/video/photo media file: Download Now |
| Posted: 11 Dec 2020 07:41 PM PST RT @JainsUSA Customer Centric Service at Jain Monitoring & Control #moreCropPerDrop @JainIrrigation jainsusa.com/training/custo… |
| Posted: 11 Dec 2020 11:50 PM PST A watch for all seasons - especially Christmas. It's Tissot of course. martin-and-co.com #christmasshopping #christmaswatches #tissotwatches This posting includes an audio/video/photo media file: Download Now |
| No longer just a soapbox for shouting out opinions. Way beyond an advertising billboard.... Posted: 11 Dec 2020 11:50 PM PST No longer just a soapbox for shouting out opinions. Way beyond an advertising billboard. Social media plays a key role in marketing, customer support, product development, & crisis management. How to exploit it? Social listening tools... ow.ly/OY0g50BgDnC |
| Sand 𝙚𝙫𝙚𝙧𝙮𝙬𝙝𝙚𝙧𝙚 ! 🤣 #AbuDhabiGP 🇦🇪 Posted: 11 Dec 2020 11:46 PM PST Sand 𝙚𝙫𝙚𝙧𝙮𝙬𝙝𝙚𝙧𝙚 ! 🤣 #AbuDhabiGP 🇦🇪 Your browser does not support the video tag. Click here to view directly. This posting includes an audio/video/photo media file: Download Now |
| Posted: 11 Dec 2020 11:46 PM PST I love audiobooks |
| Posted: 11 Dec 2020 11:45 PM PST Backend Developer (Multiple Levels Junior & Senior) @ gridX GmbH working-nomads.com/job/backend-de… #remotejobs #jobs #nomad #workfromhome #digitalnomad This posting includes an audio/video/photo media file: Download Now |
| Posted: 11 Dec 2020 11:45 PM PST |
| Posted: 11 Dec 2020 11:45 PM PST Go SDK Engineer @ Okta working-nomads.com/job/go-sdk-eng… #remotejobs #jobs #nomad #workfromhome #digitalnomad This posting includes an audio/video/photo media file: Download Now |
| Posted: 11 Dec 2020 11:45 PM PST Backend Software Engineer (Go) - Amsterdam @ Stream working-nomads.com/job/backend-so… #remotejobs #jobs #nomad #workfromhome #digitalnomad This posting includes an audio/video/photo media file: Download Now |
| Just posted a photo @ Brighton and Hove instagram.com/p/CIsJahOleA1/… Posted: 11 Dec 2020 11:45 PM PST Just posted a photo @ Brighton and Hove instagram.com/p/CIsJahOleA1/… |
| Posted: 11 Dec 2020 11:45 PM PST Software Development Engineer @ TUNE working-nomads.com/job/software-d… #remotejobs #jobs #nomad #workfromhome #digitalnomad This posting includes an audio/video/photo media file: Download Now |
| An eye for detail is her forte and analysis is what she's best at!... Posted: 11 Dec 2020 11:45 PM PST An eye for detail is her forte and analysis is what she's best at! Here's introducing the Forensic Head, Carla Rodrigues. Watch her in 'Shrikant Bashir', streaming from 11th December, only on SonyLIV. bit.ly/2VEVZ7B This posting includes an audio/video/photo media file: Download Now |
| Posted: 11 Dec 2020 11:45 PM PST Go Backend Engineer (m/f/d) @ BlueGo working-nomads.com/job/go-backend… #remotejobs #jobs #nomad #workfromhome #digitalnomad This posting includes an audio/video/photo media file: Download Now |
| Nitrogen for Crops – How Much, What Type, and When to Apply #moreCropPerDrop @JainIrrigation... Posted: 11 Dec 2020 03:41 PM PST RT @JainsUSA Nitrogen for Crops – How Much, What Type, and When to Apply #moreCropPerDrop @JainIrrigation jainsusa.com/training/nitro… |
| Posted: 11 Dec 2020 11:40 AM PST RT @JainsUSA The Components of a Drip Irrigation System #moreCropPerDrop @JainIrrigation jainsusa.com/training/the-c… |
| Posted: 11 Dec 2020 07:40 AM PST RT @JainsUSA The Many Benefits of Cooling your Apple Crop #moreCropPerDrop @JainIrrigation jainsusa.com/training/the-m… |
| Posted: 11 Dec 2020 11:43 PM PST Buone Feste ✨ Volkswagen Group : It's been a challenging year for all of us. Now it's time to wind down and get into the festive spirit. #VWGroup family wishes you Happy Holidays and a good start to the new year - stay safe and healthy! ✨ |
| Posted: 11 Dec 2020 11:42 PM PST AudioThing Wave Box Sale (Exclusive) - 80% Off 🚀 🚀 pluginboutique.com/product/2-Effe… 🙌 👍 @PluginBoutique #plugindeals #pluginsales 02:42 This posting includes an audio/video/photo media file: Download Now |
| Posted: 11 Dec 2020 03:40 AM PST RT @JainsUSA Basic Operation and Maintenance of Irrigation Pumps for Landscape Irrigation #moreCropPerDrop @JainIrrigation jainsusa.com/training/basic… |
| RT JainsUSA "Point Source or In-line Irrigation: Which one is right for my landscape?... Posted: 11 Dec 2020 12:08 AM PST RT @NSSIrrigation RT JainsUSA "Point Source or In-line Irrigation: Which one is right for my landscape? #moreCropPerDrop @JainIrrigation jainsusa.com/training/point…" |
| Posted: 11 Dec 2020 12:08 AM PST RT @NSSIrrigation RT JainsUSA "Fertilizer Management Using Today's Available Technology – Nitrogen #moreCropPerDrop @JainIrrigation jainsusa.com/training/ferti…" |
| Not the only bandits in this desert 👀 #AbuDhabiGP 🇦🇪 Posted: 11 Dec 2020 11:40 PM PST Not the only bandits in this desert 👀 #AbuDhabiGP 🇦🇪 Your browser does not support the video tag. Click here to view directly. This posting includes an audio/video/photo media file: Download Now |
| You are subscribed to email updates from twitter-atom feed for chessdiary/T-SHOP. To stop receiving these emails, you may unsubscribe now. | Email delivery powered by Google |
| Google, 1600 Amphitheatre Parkway, Mountain View, CA 94043, United States | |

No comments:
Post a Comment